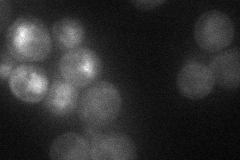
YIL015W

View description
Aspartyl protease secreted into the periplasmic space of mating type a cells, helps cells find mating partners, cleaves and inactivates alpha factor allowing cells to recover from alpha-factor-induced cell cycle arrest
Localization:
Intensity:
Fold change:
Significance:
-
C’ GFP library in SD

vacuole23.4 -
N' NOP1pr-GFP in SD
cell periphery22.0384 -
N' TEF2pr-mCherry in SD

cell periphery,vacuole7.83188 -
N' NATIVEpr-GFP in SD

below threshold18.6924 -
N' TEF2pr-VC and Cyto-VN in SD

#N/A0 -
C’ GFP library in SD+DTT

vacuole17.320.73Yes -
C’ GFP library in SD+H2O2

vacuole15.990.68Yes -
C’ GFP library in Starvation Media

vacuole17.220.73Yes -
C’ GFP library on the background of Pup2-DaMP

vacuole -
C’ GFP library on the background of CCT mutant

vacuole23.86921.01949No
